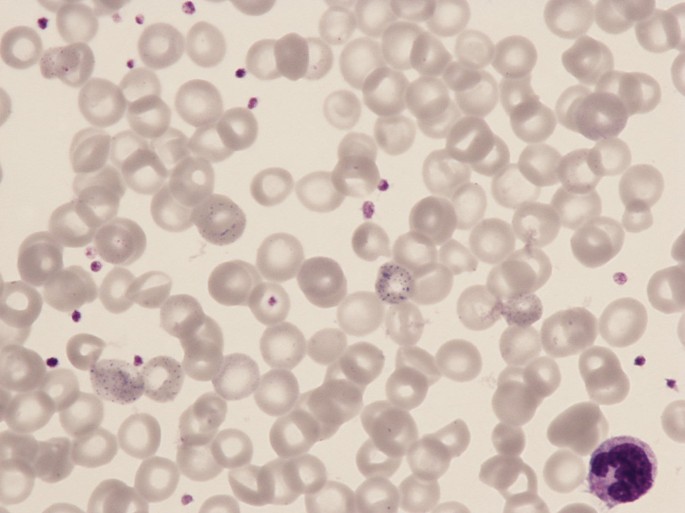
Lead Poisoning As Final Diagnosis In A Study Of Normocytic Anemia Springerlink

Lead poisoning affects adults less often than children. If the BLL is less than 25 micrograms per deciliter µgdL the anemia usually reflects iron deficiency or.

Chronic Lead Poisoning Induced Abdominal Pain And Anemia A Case Report And Review Of The Literature Bmc Gastroenterology Full Text

Lead Pb Toxicity Clinical Assessment Diagnostic Tests And Imaging Environmental Medicine Atsdr
Lead Poisoning As Final Diagnosis In A Study Of Normocytic Anemia Springerlink
Workers may develop a variety of ailments such as neurological effects gastrointestinal effects anemia and kidney disease.

Lead poisoning anemia. For example in the differential diagnosis of microcytic anemia lead poisoning can usually be ruled out by obtaining a venous blood lead concentration. Children can get lead in their bodies by breathing or swallowing lead dust or by eating soil or paint chips with lead in them. In the last 20 years statistics show the number of children with potentially harmful blood lead levels has dropped 85 percent.
Anemia is a disease where the body does not have the appropriate amount of hemoglobin or red blood cells. Learn about the health effects of lead who is at risk how to test for lead in paint or other areas of your home how to find or become a lead-safe certified firm and more about the Lead Renovation Repair and Painting RRP rule. In one analysis of lead exposures in children anemia hemoglobin lead acid car batteries and traditional remedies were the most important sources of exposure 6.
Lead exposure can harm young children and babieseven before they are born. Young children are particularly vulnerable to lead poisoning because they absorb 45 times as much ingested lead as adults from a given source. Anemia can be acute or chronic and can divide into microcytic normocytic and macrocytic.
The diagnosis of iron deficiency anemia is confirmed by the findings of low iron stores and a hemoglobin level two standard deviations below. Lead can accumulate in our bodies over time where it is stored in bones along with calcium. In rare cases ingestion of lead can cause seizures coma and even death.
While inorganic lead does not readily enter the body through the skin it can enter the body through accidental ingestion eating drinking and smoking via contaminated hands clothing and surfaces. Lead poisoning was considered to be a classic disease and the signs that were seen in children and adults were mainly pertaining to the central nervous system and the gastrointestinal tract. Lead poisoning is a totally preventable disease.
The main sources of lead exposure are lead based paints gasoline cosmetics toys household dust contaminated soil industrial emissions Gerhardsson et al 2002. Iron poisoning can also lead to diarrhea and dehydration. Sometimes too much iron causes stools to turn black and bloody.
Moreover childrens innate curiosity and their age-appropriate hand-to-mouth behaviour result in their mouthing and swallowing lead-containing or lead-coated objects such as contaminated soil or dust and. Even children who seem healthy can have high levels of lead in their bodies. Microcytic anemia can be secondary to iron deficiency lead poisoning or thalassemia.
During pregnancy lead is released from the mothers bones along with calcium and can pass from the mother exposing the fetus or the breastfeeding infant. Fanconis anemia is a blood disorder which is a familial form of aplastic anemia.

Lead Toxicity From Glazed Ceramic Cookware Cmaj
![]()
Lead Poisoning Wikipedia

Jkms Journal Of Korean Medical Science

Lead Poisoning In Pediatrics Dr Trynaadh

Sideroblastic Anemia Anemia With Ring Sideroblasts Creative Med Doses

Lead Poisoning Heme Synthesis Porphyria More The Bumbling Biochemist

Led Astray Nejm Resident 360 Meta Property Twitter Image Content Https Resident360files Nejm Org Image Upload C Fit F Auto H 120 W 120 V1538599218 U8buf4o8mgdxgmfcczjk Png Meta Property Og Image Content Https Resident360files Nejm Org
/lead-poisoning-symptoms-5ad4e3f131283400363be1dd.png)
Lead Poisoning Signs Symptoms And Complications